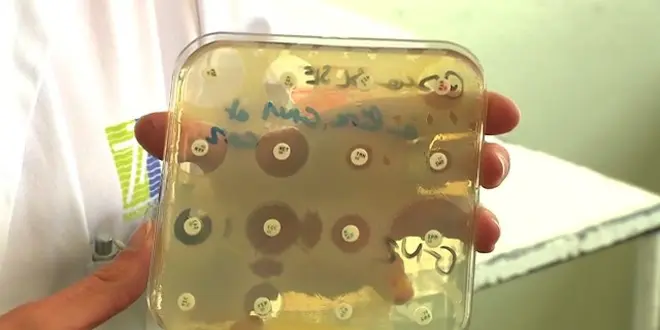

La résistance s'organise... contre l'antibiorésistance
RECHERCHE – Pour ne pas perdre le combat contre la perte d’efficacité des antibiotiques, la recherche internationale envisage plusieurs stratégies, toutes aussi différentes que complémentaires.
Rédigé le
Un état des lieux inquiétant
Chaque année en France, près de 13.000 personnes meurent d'une infection causée par des bactéries devenues multi-résistantes aux antibiotiques, soit autant que de décès liés aux maladies ou accidents cardiaques et vasculaires. À l’échelle de la planète, ce nombre dépasse aujourd’hui les 700.000. Selon des estimations sérieuses, il pourrait atteindre les 10 millions d’ici une trentaine d’années
Armes utilisées depuis près d’un siècle dans la lutte contre les bactéries pathogènes, les molécues antibiotiques sont malheureusement de moins en moins efficaces. La faute en revient aux mécanismes mêmes qui gouvernent l’évolution du vivant. En effet, lorsque des bactéries prolifèrent, elles ne se reproduisent pas nécessairement à l’identique. De façon aléatoire, des mutations (ou des emprunts à des bactéries voisines) leur confèrent des propriétés qui pourront se révéler avantageuse face à un antibiotique. Si toutes leurs congénères sont décimées grâce à un antibiotique, et ces souches isolées auront le champ libre pour fonder une dynastie qui sera, précisément, indifférente à ce traitement.
Voilà pourquoi plus nous utilisons des antibiotiques, moins ils sont efficaces. Il nous faut donc apprendre à lutter différemment contre ces pathogènes.
Six stratégies à envisager
Pour ne pas perdre le combat, multiplier les stratégies s’avère indispensable. Au-delà de la nécessaire sensibilisation des médecins, des vétérinaires et du grand public aux "bons usages" de ces médicaments (situations pertinentes, doses utiles, durée d'utilisation...), des solutions sont à l'étude dans les laboratoires. Les pistes les plus prometteuses nous ont été détaillées par Brigitte Gicquel, responsable de l’unité de Génétique mycobactérienne à l’Institut Pasteur, et par Bruno François, coordonnateur du Centre d’investigation clinique Inserm du CHU de Limoges.
Stratégie n°1 : élargir l'arsenal
Stratégie n°2 : des frappes moins puissantes, mais mieux ciblées
Stratégie n°3 : saboter les boucliers
Stratégie n°4 : laisser proliférer, mais rendre inoffensif
Stratégie n°5 : occuper rapidement le terrain avec des bactéries inoffensives
Stratégie n°6 : enrôler des virus pour des frappes chirurgicales

Stratégie n°1 : élargir l'arsenal...
Utiliser sans cesse les mêmes antibiotiques accroit la probabilité de faire émerger des bactéries qui leur sont résistantes. Il faut donc trouver de nouvelles recrues. Plusieurs laboratoires de par le monde cherchent à identifier de nouvelles molécules capables de cibler les souches bactériennes les plus dangereuses.
La technologie épaule les chercheurs : afin de déterminer quelle molécule peut interagir avec quelle(s) bactérie(s), on laisse des robots effectuer les essais à notre place. C’est la méthode de "criblage à haut débit", "qui autorise l’évaluation des centaines de milliers de combinaisons, et la découverte de quelques candidats pour des essais in vivo. "Jusqu’à présent, avec cette méthode, on a trouvé quelques antibiotiques, mais ce ne sont pas des révolutions", constate Brigitte Gicquel.
D'autres voies de recherches sont, selon elle, "prometteuses" : "plutôt que de simplement identifier des molécules qui tuent les bactéries, certains chercheurs essayent de comprendre comment elles tuent ; si l'on décortique les mécanismes d’action, si l’on comprend de quelle manière l’antibiotique altère le métabolisme de la bactérie, on identifie précisément des cibles, avant de commencer à chercher des molécules [qui pourront interagir avec elles]."
...tout en responsabilisant les usages
Toutefois, selon la chercheuse, "découvrir de nouveaux antibiotiques n'est pas un enjeu à considérer de manière isolée" : encore faut-il ne pas gaspiller cette ressource. "Lorsque des chercheurs découvrent une meilleure molécule, une forte publicité est faite dessus par l’industrie pour convaincre les médecins d’utiliser ce produit", constate Brigitte Gicquel. "Cette pression, mise durant les quelques années où le fabricant possède l’exclusivité de la molécule, fait que les nouveaux antibiotiques sont utilisées sans discernement, favorisant la sélection des résistances… Cela va littéralement « tuer » cette nouvelle molécule, et la rendre inopérante".
"Il faut absolument sortir de cette logique, sinon nous ne disposerons pas d’antibiotiques qui auront une utilité sur le long terme", déplore-t-elle. "Financer la recherche de molécules n’a de sens que dans un contexte où chacun agit de façon responsable."
Quitter ce cercle vicieux apparaît toutefois difficile, la pression pour un retour sur investissement étant mise alors même que les antibiotiques rapportent peu d’argent aux industriels "notamment parce qu’il s’agit de traitements de courte durée, ou que ces médicaments ciblent des maladies qui touchent des personnes qui ne pourront pas les acheter très cher", poursuit Brigitte Gicquel. La problématique de l’antibiorésistance a donc "une forte composante économique", explique-t-elle, "[puisque] rien ne sert de découvrir une molécule qu’aucun industriel ne va vouloir produire".
Voir également : Un nouvel antibiotique enthousiasme le monde de la recherche

Stratégie n°2 : des frappes moins puissantes, mais mieux ciblées
Pour limiter le risque d’apparition de bactéries résistantes, il faut limiter au maximum les situations dans lesquelles un antibiotique utilisé contre une infection donnée entre en contact avec des bactéries peu ou pas offensives. Beaucoup d’initiatives pourraient permettre de délivrer le médicament pertinent au plus près des agents pathogènes, durant la plus petite période de temps efficace.
Le docteur Bruno François juge "très importants" les progrès récents dans le domaine des diagnostics, "qui permettent d’identifier, presque en temps réel, les pathogènes responsables des infections". "L’idée est de mieux cibler les traitements, et d’éviter de recourir de façon systématique aux antibiotiques à large spectre" – qui éliminent de nombreuses bactéries non résistantes, qu’elles soient impliquées ou non dans l’infection.
Le problème doit être aussi envisagé dans sa dimension temporelle. "Prenons par exemple le cas de la tuberculose", illustre Brigitte Gicquel. "On aimerait bien comprendre pourquoi au bout de deux mois, si l’on arrête le traitement, environ 60% des malades sont guéris et 40% ne le sont pas. On sait que chez certains, il y a des bacilles « dormants », qui restent dans certaines cellules… Il faut approfondir notre compréhension de ces différences, car traiter un malade deux mois ou six mois, ce n’est pas pareil, notamment concernant le risque d’apparition de bactéries résistances." D’où l’importance d’étudier les marqueurs immunologiques indiquant le moment où il est pertinent d’arrêter les traitements.
Des antibiotiques en mission commando ?
Dans l’idée de toujours mieux cibler les traitements, plusieurs équipes de recherche – dont une à laquelle collabore la chercheuse de l’Institut Pasteur – étudient le moyen de transporter les traitements "au plus près des pathogènes, dans l’organisme".
"Nous développons des nanoparticules qui vont en quelque sorte « encapsuler », de façon totale ou partielle, les molécules antibiotiques". Cela peut permettre de libérer l’antibiotique de façon retardée dans l’organisme, en limitant les risques qu’il soit dégradé avant d’atteindre sa cible, "et donc de réduire les doses administrées". Mais là n’est pas l’objectif le plus ambitieux de cette technologie.
"Certaines de ces nanoparticules ont une capacité à se coller à des cellules, en fonction de marqueurs spécifiques présents à leur surface. Elles vont se rapprocher soit des bactéries, soit des cellules infectées, ou se rassembler dans certains organes. Là encore, cela peut permettre de limiter au maximum [les interactions avec d’autres bactéries présentes dans l’organisme]". Bien que la technique est déjà utilisée en cancérologie, on est encore loin d’une mise sur le marché concernant les antibiotiques. "Des résultats ont récemment été obtenus en laboratoire (contre des bacilles de la tuberculose et des streptocoques résistants à la méticilline)", précise Brigitte Gicquel, tout en rappelant les nombreux progrès qu’il reste à accomplir. "On ne sait pas encore « encapsuler » tous les antibiotiques, notamment du fait de la taille des molécules. De même, il faut s’assurer que l’antibiotique reste efficace tant qu’il n’a pas été délivré…"

Bacilles de Koch (Mycobacterium tuberculosis), bactéries responsables de la tuberculose.
Stratégie n°3 : saboter les boucliers
Les résistances acquises par les bactéries au fil des mutations peuvent être de natures diverses : paroi cellulaire plus épaisse, mécanismes permettant de rejeter les molécules intruses hors de la cellule, etc. De nombreuses équipes de recherche travaillent donc à inhiber ces mécanismes de résistance à l’aide de traitements annexes, afin de permettre aux antibiotiques de pouvoir pénétrer dans les bactéries et faire leur office.
"Des nombreuses résistances sont liées à des enzymes, les bêta-lactamases, qui dégradent l’antibiotique avant que celui-ci n’agisse", précise Bruno François. "Beaucoup de laboratoires pharmaceutiques cherchent aujourd’hui des molécules capables d’inhiber ces enzymes".
Les deux chercheurs jugent ces approches "très intéressantes". "C'est très concret, et il y a déjà un certain nombre d'inhibiteurs qui sont en phase de développement industriel", commente Brigitte Gicquel.
Voir également : Découverte d’un processus antibiotique inédit et prometteur
Stratégie n°4 : laisser proliférer, mais rendre inoffensif
Les stratégies précédentes ne constituent pas à proprement parler des alternatives aux antibiotiques, mais plutôt des moyens d’optimiser leur usage. "Des alternatives ? Oui, il y en a de crédibles", nous explique Bruno François.
"Parmi les approches les plus prometteuses se trouvent indéniablement le recours aux anticorps monoclonaux anti-infectieux", détaille le responsable du CIC de Limoges. Contrairement à un antibiotique qui va tuer une bactérie, "l’anticorps monoclonal va cibler des récepteurs, à la surface de la bactérie, associés [à la production ou à la sécrétion] des substances dangereuses pour l’organisme hôte. Il s’agit, en somme, de « désarmer » la bactérie, qui reste présente mais n’est plus incapable d’être infectieuse."
Avantage non négligeable de cette approche : contrairement aux traitements antibiotiques qui font place nette pour les bactéries résistantes, ces molécules ne contribuent pas à sélectionner des souches résistantes.
Des traitements déjà en développement
"Quelques anticorps monoclonaux anti-infectieux sont déjà sur le marché, notamment contre le Clostridium difficile", poursuit Bruno François, précisant que d’autres candidats prometteurs font l’objet d’essais cliniques. "Certains ont déjà été testés sur des volontaires sains et des personnes malades, par exemple dans le cas d’infection à Staphylococcus aureus (staphylocoque doré) ou à Pseudomonas aeruginosa. D’autres molécules sont sur le point d’être testées, notamment contre Escherichia coli ou Klebsiella pneumoniae. Au rythme actuel, il n’est pas exclu que certains de ces traitements arrivent sur le marché dans les 4 ou 5 prochaines années."
Comme les anticorps monoclonaux déjà utilisés en cancérologie ou contre certaines maladie auto-immunes, ces traitements s’administrent par voie intraveineuse. Bruno François note enfin que, comme les anticorps produits par notre propre organisme, ces molécules thérapeutiques "persistent longtemps dans l’organisme avant d’être éliminés", offrant donc aux patients "une protection qui va durer plusieurs mois, avec une seule injection".

Culture de Staphylococcus aureus (cc-by-sa HansN)
Stratégie n°5 : occuper rapidement le terrain avec des bactéries inoffensives
Les bactéries qui nous menacent ne viennent pas forcément de l’extérieur… et sont peut-être déjà dans nos bouches ou nos intestins. Nous sommes en effet porteurs de nombreuses bactéries potentiellement dangereuses pour certaines parties de notre organisme, mais sans effet délétère dans les zones où elles sont cantonnées. Ceci est d’autant plus vrai dans l’intestin, où de nombreuses espèces de bactéries cohabitent et sont en compétition. Qu’un antibiotique puissant passe par là, et les petits groupes antibio-résistants vont pouvoir se multiplier… à moins que l’on repeuple très rapidement la zone avec les espèces d’origine.
"C’est ce que l’on nomme la transplantation de flore, avec une réintroduction dans l’intestin de bactéries récupérées dans les selles du patient avant le recours à l’antibiotique, puis mises en culture", souligne Bruno François, évoquant plusieurs essais en ce sens menés, notamment en France, dans des services cancérologie. "Il reste toutefois encore difficile d’estimer l’impact que cela a, concrètement, en termes de lutte contre la prolifération de bactéries antibio-résistantes".
Bruno François note enfin l’existence de recherches concernant certains antibiotiques destinés à agir au niveau de l’intestin grêle, contre le Clostridium difficile. "Une société française, Da Volterra, a développé une méthode intéressante pour inactiver les molécules résiduelles avant leur arriver dans le côlon. Cela permet, entre autre chose, d’éviter que ces résidus d’antibiotiques ne favorisent la sélection, et donc le développement, de bactéries résistantes au niveau du côlon."

Clostridium difficile observés par microscopie électronique
Stratégie n°6 : enrôler des virus pour des frappes chirurgicales
Certains virus sont capables d’infecter et de détruire des bactéries : ce sont les virus "bactériophages" (ou "phages"). L’idée de les utiliser de façon routinière pour éliminer les pathogènes résistants aux antibiotiques est donc tentante… Pourtant, cette piste semble peu prometteuse aux spécialistes.
"Beaucoup d’espoirs ont été mis dans ces bactériophages, mais c’est un peu un « serpent de mer »", déplore Bruno François. "Ce sont des agents anti-infectieux qui sont utilisés depuis très longtemps dans certains pays de l’Est, mais sans que leur efficacité et leur sécurité aient été véritablement évalué scientifiquement. Les rares expérimentations conduites selon des standards internationaux ne sont pas extrêmement convaincantes. Il faut continuer la recherche – quelques laboratoires travaillent sur ce sujet en France – mais aujourd’hui on met peu de moyens là-dessus. Ce n’est donc pas une solution susceptible d’arriver à court terme sur le marché, tout du moins pour une utilisation de masse".
Brigitte Gicquel est tout aussi pessimiste. "Le problème est que les bactéries ciblées par les virus évoluent... Très vite apparaissent des mutations qui font qu’elles résistent aux phages. Cette piste n’est donc pas, à mon avis, très prometteuse. D’autant plus que contrôler et assurer la qualité des phages que l’on produirait [à des fins thérapeutiques] me semble très difficile".

Représentation d'un bactériophage à la surface d'une bactérie










